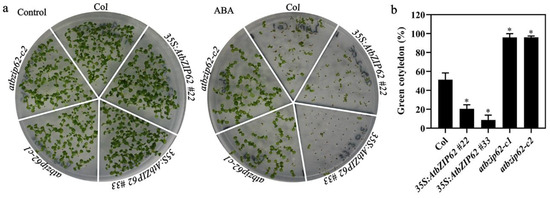

Abstract
The basic region/leucine zipper (bZIP) transcription factor AtbZIP62 is involved in the regulation of plant responses to abiotic stresses, including drought and salinity stresses, NO3 transport, and basal defense in Arabidopsis. It is unclear if it plays a role in regulating plant responses to abscisic acid (ABA), a phytohormone that can regulate plant abiotic stress responses via regulating downstream ABA-responsive genes. Using RT-PCR analysis, we found that the expression level of AtbZIP62 was increased in response to exogenously applied ABA. Protoplast transfection assays show that AtbZIP62 is predominantly localized in the nucleus and functions as a transcription repressor. To examine the roles of AtbZIP62 in regulating ABA responses, we generated transgenic Arabidopsis plants overexpressing AtbZIP62 and created gene-edited atbzip62 mutants using CRISPR/Cas9. We found that in both ABA-regulated seed germination and cotyledon greening assays, the 35S:AtbZIP62 transgenic plants were hypersensitive, whereas atbzip62 mutants were hyposensitive to ABA. To examine the functional mechanisms of AtbZIP62 in regulating ABA responses, we generated Arabidopsis transgenic plants overexpressing 35S:AtbZIP62-GR, and performed transcriptome analysis to identify differentially expressed genes (DEGs) in the presence and absence of DEX, and found that DEGs are highly enriched in processes including response to abiotic stresses and response to ABA. Quantitative RT-PCR results further show that AtbZIP62 may regulate the expression of several ABA-responsive genes, including USP, ABF2, and SnRK2.7. In summary, our results show that AtbZIP62 is an ABA-responsive gene, and AtbZIP62 acts as a transcription repressor to positively regulate ABA responses in Arabidopsis.
1. Introduction
Due to their sessile nature, plants are constantly challenged by biotic stresses, such as various pathogens and abiotic stresses, including drought and high salinity [1]. To survive, plants had to respond properly to environmental stresses. The phytohormone abscisic acid (ABA) plays a key role in regulating plant responses to abiotic stresses [2,3]. The regulation of plant responses to abiotic stresses by ABA is usually linked to osmotic stress that can promote ABA accumulation [4,5]. Whereas ABA signal transduction leads to the activation/suppression of stress-related genes, affecting plant responses to abiotic stresses [6,7].
Several ABA signaling key regulatory components have been identified, such as the ABA receptors pyrabactin resistance/PYR1 like/regulatory components of ABA receptors (PYR/PYL/RCAR), the type 2C protein phosphatases (PP2Cs), the protein kinases Snf1 (sucrose-non-fermentation 1)-related kinases subfamily 2 (SnRK2s), and the downstream ABA-responsive element binding protein/ABRE-binding factor/ABA INSENSITIVE 5 (ABF/AREB/ABI5)-type basic region leucine zipper (bZIP) transcription factors [6,7,8,9,10,11,12]. Signal transduction through the PYR/PYL/RCABR receptors, the PP2C phosphatases, and the SnRK2 kinases activate the ABF/AREB/ABI5-type bZIP transcription factors, resulting in the activation or repression of downstream ABA response genes, and thereby changes of plant responses to abiotic stresses [6,7,13,14,15,16].
In addition to the ABF/AREB/ABI5-type bZIP transcription factors, sever other transcription factors have also been reported to be involved in regulating ABA signaling. For example, APETALA2/ETHYLENE RESPONSIVE FACTOR (AP2/ERF), basic/helix-loop-helix (bHLH), Homeodomain-leucine zipper (HD-Zip), MADS-box, MYB, NAC, GARP (Golden2, ARR-B, Psr1), WRKY, AITR (ABA-induced transcription repressor) and the WDR (WD40-repeat) proteins [17,18,19,20].
The bZIP family transcription factors are characterized by a highly conserved bZIP domain and one of the biggest transcription factor families [12,21]. There are 75 bZIP transcription factors in Arabidopsis, 50 of which have not yet been functionally characterized [22]. Further comprehensive analyses identified two additional bZIP transcription factors in Arabidopsis [23]. It has been shown that bZIP transcription factors in plants mainly recognize ACGT core motif-containing cis-acting DNA elements, such as TACGTA (A-box), GACGTC (C-box), and CACGTG (G-box) [12,24,25]. The bZIP family proteins in Arabidopsis regulate different physiological processes in plants, including seed germination, floral growth and fertility, plant senescence, responses to abiotic stresses, and ABA signal transduction [26]. As examples, AtbZIP9, AtbZIP12 & 39, AtbZIP14/FD, AtbZIP18, AtbZIP29, AtbZIP30, AtbZIP34, and AtbZIP44 are all involved in regulating plant development [27,28,29,30,31]. In particular, leaf senescence, a controlled developmental process that has a significant impact on food crop productivity and nutritional content [32,33], is also regulated by several bZIP transcription factors, including AtbZIP1, AtbZIP36/ABF5, AtbZIP37/ABF3, AtbZIP38/ABF4/AREB2), AtbZIP41 and AtbZIP53 [32,34,35]. In addition, some bZIP transcription factors, such as AtbZIP56, are also involved in regulating plant metabolism [36]. So far, a number of bZIP transcription factors, such as AtbZIP1, AtbZIP17, AtbZIP24, AtbZIP35/ABF1, AtbZIP36/ABF2/AREB1, AtbZIP51, and AtbZIP62 have been found to regulate plant abiotic and biotic stress responses in Arabidopsis [37,38,39,40,41,42,43,44].
AtbZIP62 has been previously shown to regulate plant responses to abiotic stresses such as drought [45] and salinity [44]. AtbZIP62 also plays a role in regulating NO3 transport [46] and acts as a negative regulator of basal defense [47]. In this study, we show that AtbZIP62 is involved in regulating ABA response in Arabidopsis. We found that AtbZIP62 is an ABA inducible gene, AtbZIP62 functions as a transcription repressor, and Arabidopsis plants overexpressing AtbZIP62 are more sensitive, while atbzip62 mutants are less sensitive to ABA.
2. Results
2.1. Expression of AtbZIP62 in Response to ABA and in Different Tissues and Organs
ABA regulates plant responses to abiotic stresses via activation/suppression of downstream genes [6,7]. Previous experiments have shown that the AtbZIP62 is involved in the regulation of plant responses to abiotic stresses such as drought and salinity [44,45]. To examine if ABA can regulate the expression of AtbZIP62, we compared the expression levels of AtbZIP62 in Arabidopsis seedlings treated with ABA and control samples. RNA was extracted from Arabidopsis seedlings treated with ABA or solvent for 4 h, and the expression of AtbZIP62 was determined using RT-PCR. As shown in Figure 1a, exogenous application of ABA significantly increased the expression level of AtbZIP62 when compared to the mock-treated control.

Figure 1.
Expression of AtbZIP62 in response to ABA treatment and in different tissues and organs. (a) Expression of AtbZIP62 in response to ABA treatment. Col wild-type seedlings of10-day-old were treated for 4 h with 50 μM ABA, RNA was isolated and used for RT-PCR to examine the expression of AtbZIP62. ACT2 was used as a control for RT-PCR. (b) Expression pattern of AtbZIP62. Different tissues and organs were collected from the Col wild-type Arabidopsis plants. RNA was isolated and used for RT-PCR to examine the expression of AtbZIP62. ACT2 was used as a control gene for RT-PCR.
We also examine the expression patterns of AtbZIP62. RNA was isolated from different tissues and organs collected from Col wild-type Arabidopsis plants and used for RT-PCR analysis. As shown in Figure 1b, the transcripts of AtbZIP62 were detectable in all the tissues and organs examined with almost similar expression levels.
2.2. AtbZIP62 Is a Transcription Repressor
As AtbZIP62 is a transcription factor whose transcriptional activities have not been tested, we examined the transcription activities using Arabidopsis protoplast transfection. We first examined the subcellular localization of AtbZIP62. Plasmids of GFP-AtbZIP62 and NLS-RFP, a nuclear marker gene construct, were co-transfected into Arabidopsis protoplasts, and the fluorescence of GFP and RFP were examined under a fluorescence microscope. As shown in Figure 2a, GFP fluorescence was predominantly observed in the nucleus.

Figure 2.
Subcellular localization and transcriptional activities of AtbZIP62. (a) Subcellular localization of AtbZIP62. Plasmids of the effector GFP-AtbZIP62 and the nuclear marker gene NLS-RFP were co-transfected into Arabidopsis protoplasts isolated from leaves of the Col wild-type plants. The transfected protoplasts were incubated in the dark at room temperature for 20–22 h, and GFP and RFP fluorescence was observed and photographed under a confocal microscope. (b) Transcriptional activities of Arabidopsis AtbZIP62. Plasmids of the GD-AtbZIP62 effector, the LD-VP activator, and the LexA-Gal4:GUS reporter constructs were co-transfected into Arabidopsis protoplasts isolated from the Col wild-type plants, the transfected protoplasts were incubated in darkness for 20–22 h, and then GUS activity was assayed by using a microplate reader. Co-transfection of the GD construct plasmids served as a control. Data represent the mean ± SD of three replicates. * significantly different from the GD control (student’s t-test, p < 0.001).
After showing that AtbZIP62 is a nucleus protein, we examined its transcriptional activities using a protoplast transfection system successfully used to study transcription repressors [48]. Plasmids of the reporter construct LexA-Gal4:GUS, the activator construct LD-VP, and the effector construct GD-AtbZIP62 or the control construct GD were co-transfected into Arabidopsis protoplasts. After overnight incubation of the transfected protoplasts in the dark, GUS activities were measured using a microplate reader. As shown in Figure 2b, co-transfection of LD-VP and GD activated the reporter gene, whereas co-transfection of LD-VP with GD-AtbZIP62 resulted in repressed expression of the reporter gene, suggesting that AtbZIP62 functions as a transcription repressor.
2.3. Generation of the 35S:AtbZIP62 and the 35S:AtbZIP62-GR Transgenic Plants, and the Gene-Edited atbzip62 Mutants
To examine the functions of AtbZIP62, we generated plants overexpressing AtbZIP62 under the control of 35S promoter (35S:AtbZIP62) and CRISPR/Cas9 gene-edited atbzip62 mutants.
CRISPR/Cas9 mediated genome editing was used to generate the atbzip62 mutants. Two target sites in the exon of AtbZIP62 were selected, and the corresponding sequence was used to generate the pHEE-FT-AtbZIP62 construct using the pHEE-FT vector [49]. The construct was transformed into the Col wild-type Arabidopsis plants. Editing status in early bolting T1 plants was examined, and Cas9-free homozygous mutants were isolated from T2 plants. Two independent homozygous mutants were chosen for further experiments. In the atbzip62-c1 mutant, a deletion of 825 nucleotides fragment occurred in AtbZIP62 (Figure 3a), resulting in a 275 amino acids deletion (Figure 3b). In the atbzip62-c2 mutant, a single nucleotide was inserted in AtbZIP62 (Figure 3a), leading to the substitution of a few amino acids and a premature stop in AtbZIP62 (Figure 3b).

Figure 3.
Generation of the transgenic overexpression lines and gene-edited mutants of AtbZIP62. (a) Editing status of AtbZIP62 in the atbzip62 mutants. DNA was isolated from leaves of T2 plants with normal flowering and used for RT-PCR amplification of AtbZIP62 and sequencing. The underlines indicate the PAM sites, the open arrow end indicates the site where fragment deletion occurred, and the star indicates the single nucleotide inserted. (b) Amino acid alignment of AtbZIP62 in the Col wild type plant and the atbzip62 mutants. The ORFs of AtbZIP62 in the atbzip62 mutants were identified using ORF finder (https://www.ncbi.nlm.nih.gov/orffinder, accessed on 9 December 2020), and corresponding amino acid sequences were aligned with the amino acid sequence of AtbZIP62. (c,d) Expression of AtbZIP62 in the 35S:AtbZIP62 & 35S:AtbZIP62-GR transgenic plants. Total RNA was isolated from seedlings of 10-day-old homozygous transgenic plants and used for RT-PCR analysis to examine the expression of AtbZIP62. ACT2 was used as a control.
The 35S:AtbZIP62 overexpression transgenic plants were generated by transforming the Col wild-type Arabidopsis plants with pPZP211-35S:AtbZIP62. In the T3 generation, homozygous plants were selected, and the expression level of AtbZIP62 in homozygous transgenic plants was examined. The #22 and #33, two independent lines with similar expression levels of the AtbZIP62 gene (Figure 3c), were selected and used for the following experiments. To examine genes that may be regulated by AtbZIP62, we generated 35S:AtbZIP62-GR transgenic plants, in which the AtbZIP62 protein was fused with the glucocorticoid receptor (GR) (Figure 3d).
2.4. AtbZIP62 Positively Regulates ABA Response in Arabidopsis
Having shown that AtbZIP62 is an ABA-responsive gene (Figure 1a), we further explored the functions of AtbZIP62 in regulating ABA responses in Arabidopsis by using the overexpression transgenic plants and mutants generated. ABA-inhibited seed germination and cotyledon greening assays were used to examine ABA responses of the Col wild-type, the 35S:AtbZIP62 transgenic plants, and the atbzip62 mutants. In the seed germination assays, we found that seed germination of different genotypes was similar in the absence of ABA, i.e., almost all the seeds germinated 36 h after the plates were transferred to the growth room (Figure 4). In the presence of ABA, however, lower germination rates were observed for seeds of the 35S:AtbZIP62 transgenic plants, whereas higher germination rates were observed for seeds of the atbzip62 mutants at all the time points examined (Figure 4), indicating that ABA sensitive was reduced in the atbzip62 mutants but increased in the 35S:AtbZIP62 transgenic plants.

Figure 4.
Effect of ABA on seed germination of the Col wild type, the 35S:AtbZIP62 transgenic plants, and the atbzip62 mutants. Sterilized seeds were sown on 1/2 MS plates with or without 1 μM ABA, kept at 4 °C and in darkness for 2 days, and then transferred to a growth room. The number of germinated seeds was counted every 12 h after the transfer until all the seeds were germinated. The percentage of seed germination was then calculated. Data represent the mean ± SD of three replicates.
Similar results were obtained in the cotyledon greening assays. As shown in Figure 5a, in the presence of ABA, the numbers of green seedlings of the 35S:AtbZIP62 transgenic overexpression plants were lower than those of Col wild type plants, while that of the atbzip62 mutant plants were clearly higher than those of Col wild type plants. Quantitative results show that at the present of ABA, the cotyledon greening rate for the Col wild type was ~50%, that for the 35S:AtbZIP62 transgenic plants was ~20%, whereas that for the atbzip62 mutants was ~100% (Figure 5b). These results suggest that AtbZIP62 positively regulates ABA responses in Arabidopsis.
Figure 5.
Effects of ABA on cotyledon greening of Col wild type, the 35S:AtbZIP62 transgenic plants and the atbzip62 mutants. (a) Cotyledon greening of Col wild type, the 35S:AtbZIP62 transgenic plants, and the atbzip62 mutants in the presence and absence of ABA. Sterilized seeds were sown on 1/2 MS plates in the presence or absence of 1 μM ABA. After being kept at 4 °C in darkness for 2 days, the plates were transferred to a growth room. Pictures were taken 8 days after the transfer. (b) Quantitative assays of cotyledon greening of the Col wild type, the 35S:AtbZIP62 transgenic plants, and the atbzip62 mutants in the presence of 1 µM ABA. Seedlings with green cotyledons were counted 8 days after the transfer, and the percentage of green seedlings was calculated. Data represent means ± SD of three replicates. * significantly different from that of the Col wild type (student’s t-test, p < 0.005).
2.5. AtbZIP62 Regulated Genes Are Enriched in Response to ABA
To explore the functional mechanism of AtbZIP62 in regulating ABA response in Arabidopsis, we decided to investigate the downstream gene whose response to ABA may be regulated by AtbZIP62. We, therefore, generated the 35S:AtbZIP62-GR transgenic plants (Figure 3d) and used them for transcriptome analysis.
In transgenic plants, the fusion proteins cannot enter the nucleus in normal conditions and are not functional, but they can enter the nucleus when treated with dexamethasone (DEX), and AtbZIP62 can regulate the expression of its downstream genes. We, therefore, performed comparative transcriptome analysis with 10-day-old seedlings of the 35S:AtbZIP62-GR plants treated with 50 µM ABA and 50 µM ABA + 10 µM DEX for 4 h. Since AtbZIP62 functions as a transcriptional repressor (Figure 2b), we focus on the genes that were down-regulated in ABA + DEX-treated seedlings.
A total of 231 different expressed genes (DEGs) were found down-regulated by ABA + DEX treatment in 35S:AtbZIP62-GR transgenic plant seedlings (Table S1). Gene ontology (GO) term enrichment analysis reveals that these genes were enriched in several different processes such as transport, including nitrate transport, chloride transmembrane transport, calcium ion transmembrane transport, biosynthetic process (including ethylene biosynthetic, thiamine biosynthetic, and cinnamic acid biosynthetic), and fatty acid biosynthetic, regulation of DNA-template transcription, regulation of seed germination, glucose-mediated signaling pathway, and responses to environmental stimuli including wounding cold and salt stress. However, the genes were mostly enriched in response to ABA (Figure 6, Table S1).

Figure 6.
Functional categorization of the differentially expressed genes. Function categorization of the DEGs down-regulated in ABA + DEX treated 35S:AtbZIP62-GR transgenic plant seedlings. DEGs down-regulated in ABA + DEX treated 35S:AtbZIP62-GR transgenic plant seedlings were subject to Gene Ontology (GO) biological enrichment by using the pHyper function in R software and estimated by hypergeometric test. Adjusted p-values (−log10 or Q-values) depicting significant enrichment (q-value < 0.05).
2.6. AtbZIP62 Regulates ABA-Induced Expression of Some ABA and Abiotic Stress Response Regulator Genes
Among the DEGs down-regulated in ABA + DEX treated 35S:AtbZIP62-GR transgenic plant seedlings, several genes, including USP, SnRK2.7, and ABF2, have been well studied and are known to be related to ABA and abiotic stress responses. The expression of USP, a universal stress protein gene, is induced by ABA, and ABA sensitivity in the atusp mutant was increased, as indicated by seed germination assays [50]. SnRK2.7 responds strongly to osmotic stress and ABA [51], whereas ABF2 is a master regulator of ABA signaling, and the expression of ABF2 is induced by ABA [33]. We, therefore, examined their expression in ABA and ABA + DEX treated 35S:AtbZIP62-GR transgenic plant seedlings using qRT-PCR. As shown in Figure 7a, ABA response of all three genes was reduced, consistent with the transcriptome data (Table S1). We also examined the ABA-induced expression of USP, SnRK2.7, and ABF2 in the 35S:AtbZIP62 transgenic plant and the atbzip62 mutant seedlings, and found that ABA-induced expression of all three genes was reduced in the 35S:AtbZIP62 transgenic plant seedlings (Figure 7b).

Figure 7.
AtbZIP62 affects ABA-induced expression of USP, SnRK2.7, and ABF2. (a) ABA-induced expression of USP, SnRK2.7, and ABF2 in ABA and ABA + DEX treated 35S:AtbZIP62-GR transgenic plant seedlings. Ten-day-old seedlings of 35S:AtbZIP62-GR transgenic plants were treated with 50 μM ABA in the presence and absence of 10 μM DEX for 4 h. RNA was then isolated and used for qRT-PCR analysis. ACT2 was used as an inner control, and fold changes were calculated by comparing the expression levels of the corresponding genes in ABA-treated with control seedlings in the presence and absence of DEX, respectively. Data represent the mean ± SD of three replicates. * significantly different from ABA-treated seedlings (student’s t-test, p < 0.005). (b) ABA-induced expression of USP, SnRK2.7, and ABF2 in the 35S:AtbZIP62 transgenic plant and atbzip62 mutant seedlings. Seedlings of 10-days-old Col wild type, the 35S:AtbZIP62 transgenic plants, and the ztbzip62 mutants were treated with 50 μM ABA for 4 h. RNA was then isolated and subjected to qRT-PCR analysis. ACT2 was used as an inner control, and fold changes were calculated by comparing the expression levels of the corresponding genes in ABA-treated with control seedlings. Data represent the mean ± SD of three replicates. * significantly different from that in the Col wild-type seedlings (student’s t-test, p < 0.05).
3. Discussion
The bZIP transcription factor family is one of the largest transcription factor plant families and is involved in the regulation of a wide range of biological activities, including plant growth, development, and responses to abiotic and biotic stresses [22]. So far, several bZIP transcription factors, especially those from group A, including bZIP36/ABF2, bZIP37/ABF3, and bZIP38/ABF4 have been shown to be involved in the regulation of plant abiotic stress responses via regulating ABA responses [15,52,53]. It has been previously shown that AtbZIP62, a group V bZIP transcription factor [54], regulates plant responses to abiotic stresses such as drought and salinity [44,45]. We provide evidence here that AtbZIP62 is an ABA-responsive gene, and AtbZIP62 regulates ABA responses in Arabidopsis.
It has been shown that the expression of AtbZIP36 and AtbZIP38 genes were induced by high-salt and ABA treatments [55]. Our data indicate that the expression level of AtbZIP62 is significantly increased in response to exogenous ABA treatment (Figure 1a). To understand the roles of the AtbZIP62 gene in Arabidopsis, we analyzed the expression pattern of the AtbZIP62 in different tissues and organs, and found that AtbZIP62 expressed at almost similar levels in all the tissues and organs examined (Figure 1b). The results suggest that AtbZIP62 may not play a particular role in plant growth and development. Protoplast transfection assays indicated that AtbZIP62 is a nuclear protein (Figure 2a) and can reduce the expression of the reporter gene activated by a transcription activator, indicating that AtbZIP62 is a transcription repressor (Figure 2b). This observation is consistent with the observation that most bZIP proteins are exclusively localized in the nucleus to exert their function as transcription factors [56].
It has been shown that ABA is involved in regulating seed dormancy, seed germination, and seedling growth [57] and that abiotic stresses can induce ABA biosynthesis and trigger ABA-dependent signaling transduction [58]. So far, most bZIPs that bind to ABREs, such as ABI5, ABRE1/ABF2, ABRE2/ABF4, and ABF1, are reported to belong to group A in bZIP transcription factors in Arabidopsis, and their gene expression is strongly induced by ABA and abiotic stresses [59,60]. A previous study investigated that AREB1 and AREB2 are the most well-known bZIP transcription factors that act as fundamental components in regulating ABRE-dependent gene expression. Overexpression analysis reveals that ABF2, ABF3, ABF4, and ABI5 transgenic plants are more sensitive to ABA during seed germination and later growth stage [61,62]. Our results suggest that group V bZIP transcript factor AtbZIP62 also positively regulates ABA response in Arabidopsis, as the transgenic plants overexpressing AtbZIP62 showed a hypersensitivity, while the atbzip62 mutant showed a hyposensitivity response to ABA in both seed germination and green cotyledon assays (Figure 4 and Figure 5a,b).
Previous research has revealed that Arabidopsis bZIPs play various roles in plant growth, environmental signaling, and stress response [26]. Transcriptomic analysis revealed that DEGs downregulated in ABA + DEX treated 35S:AtbZIP62-GR transgenic plant seedlings enriched in biological processes such as response to abscisic acid, wounding, and abiotic stimulus (Figure 6, Table S1). ABA-responsive genes within these clusters, including USP, SnR2.7, and ABF2, whose expression levels in response to ABA are significantly reduced in the 35S:AtbZIP62-GR transgenic plants treated with DEX (Figure 7a). Therefore, it can be speculated that AtbZIP62 overexpression affected ABA-regulated gene expression, which, in turn, affected plant response to abiotic stresses, as reported previously [44,45]. In addition, the results shown in Figure 7b indicate that the expression of USP, SnRK2.7, and ABF2 in response to ABA was affected in the AtbZIP62 overexpress lines and the atbzip62 mutants. Considering that USP and ABF2 are regulated by phytohormones and involved in regulating seed germination in Arabidopsis [42,50], it is likely that AtbZIP62 regulates seed germination via regulating the expression of USP and ABF2.
4. Materials and Methods
4.1. Plant Materials and Growth Conditions
The Columbia-0 (Col) wild-type Arabidopsis (Arabidopsis thaliana) stored in our lab was used as a control for gene expression pattern and ABA sensitivity assays, for protoplasts isolation, and for plant transformation to generate transgenic overexpression plants and gene-edited mutants.
For ABA treatment, gene expression analysis, transcriptome analysis, seed germination, and cotyledon greening assays, seeds of the Col wild-type, the AtbZIP62 and AtbZIP62-GR transgenic plants, and the atbzip62 mutants were surface sterilized, rinsed with sterilized water, and then sowed on ½ MS (Murashige and Skoog) plates containing 1% sucrose and 0.6% agar. The plates were incubated in darkness at 4 °C for two days before being transferred to a growth room. For gene expression pattern assay, protoplast isolation, and plant transformation, the Col wild-type seeds were germinated and grown in soil pots in a growth room. The growth room conditions were set at 22 °C with a light density of ~120 μmol m−2 s −1 under 16/8 h light/dark conditions.
4.2. DNA and RNA Isolation, RT-PCR, and Quantitative RT-PCR (qRT-PCR)
DNA and total RNA were extracted, and cDNA was synthesized as previously described [63,64]. In brief, the total RNA in the samples collected was isolated by using the EasyPure Plant RNA Kit (TransGene Biotech, Beijing, China), and cDNA was synthesized by using the EasyScript FirstStrand DNA Synthesis Super Mix (TransGen Biotech, Beijing, China) according to the manufacturer’s protocols. DNA was isolated using a DNA isolation buffer, as described previously [65].
For expression pattern assay of AtbZIP62, tissues and organs were collected from Col wild-type Arabidopsis plants grown in soil pots. To examine the expression of AtbZIP62 in response to ABA treatment, ABA-treated and control seedlings were collected. To examine the expression of AtbZIP62 in the overexpression of transgenic plants, seedlings of homozygous transgenic plants were collected. The collected samples were frozen in liquid N2 immediately and stored at −80 °C for RNA isolation.
To examine gene editing status, DNA was extracted from the leaves of T1 or T2 transgenic plants. DNA isolated from T1 transgenic plants was used for PCR amplification of AtbZIP62 genome sequences. The PCR products were isolated and sequenced, and the sequencing results were aligned with the wild-type AtbZIP62 sequence to select the gene-edited T1 transgenic plants. DNA isolated from T2 progeny of the altered T1 plants was used for PCR amplification to isolate Cas9-free homozygous mutants. The primers used to amplify the AtbZIP62 genomic sequence are AtbZIP62-F 5′-ATGGAGTTGGAGCCTATATCA-3′ and AtbZIP62-R 5′-TTATCCGACCTGCATCC-3′. The primers used for PCR amplification of Cas9 have been described previously [66].
The expression of AtbZIP62 in response to ABA treatment, the expression pattern of AtbZIP62 in different tissues of the Col wild-type plants, and the expression level of AtbZIP62 in the overexpression transgenic plants were examined by using RT-PCR. The expression of ABA inducible genes, i.e., USP, Snrk2.7, and ABF2, was examined using qRT-PCR. ACTIN2 (ACT2) was used as a control for RT-PCR and qRT-PCR. The qRT-PCR primer are, USP, 5′-GGAGACGGCTGCAAATAAGA-3′ and 5′-CCGGTTCGGCACTAATAACA-3′, SnRK2.7, 5′-GAAGATCCACGGAACATTAG-3′ and 5′-CAACACTCTGTCGACACTTC-3′, ABF2, 5′-TTGGGGAATGAGCCACCAGGAG-3′, and 5′-GACCCAAAATCTTTCCCTACAC-3′. The primers used for RT-PCR and quantitative RT-PCR (qRT-PCR) analysis of ACT2 have been described previously [67].
4.3. Constructs
The reporters construct LexA-Gal4:GUS, the effector constructs GD, LD-VP and the NLS-RFP nuclear indicator construct for protoplast transfection were described previously [68,69,70].
To generate GD-AtbZIP62 and GFP-AtbZIP62 constructs, the full-length open reading frame (ORF) of AtbZIP62 was RT-PCR amplified using RNA isolated from 10-day-old Col seedlings as described previously [63,64] and cloned into the pUC19 vector under the control of the CaMV 35S promoter, and in frame with an N-terminal GD tag for transcriptional activity assay or a GFP tag for subcellular localization assay.
To generate 35S:AtbZIP62 constructs, the full-length ORF sequence of AtbZIP62 was amplified and cloned into the pUC19 vector with an in-frame N-terminal HA tag and under the control of the 35S promoter [68,71]. To generate the 35S:AtbZIP62-GR construct for plant transformation, the full-length ORF of AtbZIP62 without stop codon was PCR amplified and cloned in frame with an N-terminal HA tag a C-terminal GR tag into pUC19 vector. The pUC19-35S:AtbZIP62 and pUC19-35S:AtbZIP62-GR constructs were digested with corresponding restriction enzymes and then cloned, respectively, into the binary vector pPZP211 [72]. The primers (underlines indicate enzyme sites) used to amplify AtbZIP62 were 5′-CAACATATGGAGTTGGAGCCTATATCA-3′ and 5′-CAAGAGCTCTTATCCGACCTGCATCC-3, the reverse primer used to amplify AtbZIP62 without stop codon was 5′-CAAGAGCTCTCCGACCTGCATCCGAC-3′.
To generate AtbZIP62 gene editing CRISPR/Cas9 constructs, potential target sequences were identified on CRISPRscan (http://www.crisprscan.org/?page=sequence, accessed on 1 September 2019) by scanning the exon sequences of AtbZIP62 and then evaluated their specificity on Cas-OFFinder (http://www.rgenome.net/cas-offinder, accessed on 1 September 2019). The specific target sequences selected for editing AtbZIP62 are 5′-GAAGTAAAGGGAAACGGGTG(AGG)-3′ and 5′- GGGCTTCAAGATACACAAAG(AGG)-3′. The target sequences were inserted into the previously described pHEE-FT vector [49]. The primers (underlines indicated the target sequences) used to generate AtbZIP62 gene editing CRISPR/Cas9 construct were DT1-BsF 5′-ATATATGGTCTCGATTGAAGTAAAGGGAAACGGGTGGTT-3′ and DT1-F0 5′-TGAAGTAAAGGGAAACGGGTGGTTTTAGAGCTAGAAATAGC-3′, DT2-R0 5′-AACCTTTGTGTATCTTGAAGCCCAATCTCTTAGTCGACTCTAC-3′ and DT2-BsR 5′-ATTATTGGTCTCGAAACCTTTGTGTATCTTGAAGCCCAA-3′. U626-IDF and U629-IDR, the primers used for colony PCR and sequencing the generated CRISPR/Cas9 construct, have been described previously [73].
4.4. Plasmid DNA Isolation, Protoplasts Isolation, Transfection, GFP and RFP Fluorescence Observation, and GUS Activity Assays
Plasmid isolation, Arabidopsis protoplast isolation, transfection and incubation, GFP inflorescence observation, and GUS activity assays were performed as described previously [63,74,75,76]. In brief, plasmid DNA including GFP-AtbZIP62, NLS-RFP, GD, GD-AtbZIP62, LD-VP, and LexA-Gal4:GUS were isolated by using a GoldHi EndoFree PlasmidMaxi Kit (CWBIO, Taizhou, China) as instructed by the manufacturer, and protoplasts were isolated from rosette leaves collected from 3 to 4-week-old Col wild type plants.
For the subcellular localization assay, plasmids of the effector construct GFP-AtbZIP62 and nuclear indicator construct NLS-RFP were co-transfected into the Arabidopsis protoplasts. For the transcriptional activity assays, the reporter plasmid construct LexA-Gal4:GUS, the activator construct LD-VP, and the effector construct GD-AtbZIP62, or the control construct GD, were co-transfected into Arabidopsis protoplasts. The transfected Arabidopsis protoplasts were incubated at room temperature for 18–22 h in darkness. Fluorescence of GFP and RFP was observed under a fluorescent microscope (Olympus, Tokyo, Japan), and GUS activities were measured using a Synergy HT fluorescence microplate reader (BioTEK, Vermont, USA).
4.5. Plant Transformation and Transgenic Plants Selection
Col wild-type plants about 5-week-old and with several mature flowers on the main inflorescence stems were used for transformation by using the floral dip method [77]. The plants were transformed with the 35S:AtbZIP62, the 35S:AtbZIP62-GR, and the CRISPR/Cas9 constructs via GV3101 agrobacterium cells to obtain transgenic overexpression plants, as well as gene-edited mutants for gene AtbZIP62.
To select transgenic plants, T1 seeds were collected from the transformed plants and plated on ½ MS plates containing 100 μg/mL carbenicillin and 50 μg/mL kanamycin, and the transgenic plants selected were transplanted to soil pots and grown in a growth room. For 35S:AtbZIP62 and 35S:AtbZIP62-GR overexpression plants, multiple homozygous lines were obtained, and the ones with high expression levels of AtbZIP62 were used for the experiments.
The atbzip62 Cas9-free gene-edited mutants were obtained by following the procedure described previously [49]. Briefly, the editing status of the AtbZIP62 gene in T1 plants with early flowering phenotypes was examined. T2 seeds were collected from gene-edited T1 plants and sowed directly into soil pots, and the editing status of the AtbZIP62 gene in the normal flowering (Cas9-free) was examined to identify homozygous mutants. Cas9-free status was further confirmed by amplifying the Cas9 fragment in the homozygous mutants.
4.6. ABA Treatment
To examine the expression of AtbZIP62 in response to ABA treatment, seedlings of 10-day-old Col wild-type plants were transferred to a 50 mL falcon tube containing 50 µM ABA and shaken in the dark for 4 h. To examine the expression of USP, SnRK2.7, and ABF2 in Col wild-type, the 35S:AtbZIP62 transgenic plants and the atbzip62 mutant, seedlings of 10-day-old Col wild type, the 35S:AtbZIP62 transgenic plants and the atbzip62 mutants were treated with 50 µM ABA for 4 h.
4.7. Seed Germination and Cotyledon Greening Assays
For phenotypic analysis, seeds were germinated and grown on ½ MS supplemented with or without 1 μm ABA. Seed germination was judged based on the emergence of an embryonic axis protrusion. Cotyledon greening was judged based on observing cotyledon expansion and turning green. Three independent experiments were carried out, and similar results were obtained.
4.8. Transcriptome Analysis
For transcriptome analysis, 10-day-old seedlings of the 35S:AtbZIP62-GR transgenic plants were transferred to a falcon tube and treated for 4 h with 50 µM ABA or 50 µM ABA + 10 µM DEX, frozen in liquid N2 and sent to the company, Beijing Genomics Institute for transcriptome sequencing and analysis.
Down-regulated DEGs in ABA + DEX treated vs. ABA treated seedlings were subject to functional Gene Ontology (GO) under the term of biological process. The pHyper function in R software was used and estimated by hypergeometric test for the gene ontology (GO) annotation enrichment of DEGs analysis. GO terms with a Q value (corrected p-value) equal to 0.05 were considered significantly enriched.
5. Conclusions
Our results in this study show that AtbZIP62 is an ABA-responsive gene. AtbZIP62 functions as a transcription repressor and positively regulates ABA responses in Arabidopsis, possibly via regulating the expression of some ABA signaling regulator genes.
Supplementary Materials
The following supporting information can be downloaded at: https://www.mdpi.com/article/10.3390/plants11223037/s1, Table S1: Genes downregulated in the ABA + DEX group in the 35S:AtbZIP62-GR transgenic plants.
Author Contributions
Conceptualization, S.W. and T.W.; methodology, S.H.; investigation, S.H., Y.C., Y.L., W.W., H.T., N.Z., Y.W., Y.Y., H.H., R.L., and C.W.; data curation, S.H. and S.W.; writing–original draft preparation, S.H. and S.W.; writing–review and editing, all the co-authors; supervision, S.W.; project administration, T.W. and S.W.; funding acquisition, S.W. All authors have read and agreed to the published version of the manuscript.
Funding
This research was funded by the National Nature Science Foundation of China (32071938) and a startup fund from Linyi University (LYDX2019BS039).
Data Availability Statement
All data are presented in the manuscript and the supplementary material.
Conflicts of Interest
The authors declare no conflict of interest.
References
- Bohnert, H.J.; Nelson, D.E.; Jensen, R.G. Adaptations to environmental stresses. Plant Cell 1995, 7, 1099–1111. [Google Scholar] [CrossRef] [PubMed]
- Mang, H.G.; Qian, W.; Zhu, Y.; Qian, J.; Kang, H.G.; Klessig, D.F.; Hua, J. Abscisic acid deficiency antagonizes high-temperature inhibition of disease resistance through enhancing nuclear accumulation of resistance proteins SNC1 and RPS4 in Arabidopsis. Plant Cell 2012, 24, 1271–1284. [Google Scholar] [CrossRef] [PubMed]
- Capelle, V.; Remoué, C.; Moreau, L.; Reyss, A.; Mahé, A.; Massonneau, A.; Falque, M.; Charcosset, A.; Thévenot, C.; Rogowsky, P. QTLs and candidate genes for desiccation and abscisic acid content in maize kernels. BMC Plant Biol. 2010, 10, 2. [Google Scholar] [CrossRef]
- Nakashima, K.; Ito, Y.; Yamaguchi-Shinozaki, K. Transcriptional regulatory networks in response to abiotic stresses in Arabidopsis and grasses. Plant Physiol. 2009, 149, 88–95. [Google Scholar] [CrossRef] [PubMed]
- Zhu, J.K. Abiotic stress signaling and responses in plants. Cell 2016, 167, 313–324. [Google Scholar] [CrossRef] [PubMed]
- Umezawa, T.; Nakashima, K.; Miyakawa, T.; Kuromori, T.; Tanokura, M.; Shinozaki, K.; Yamaguchi-Shinozaki, K. Molecular basis of the core regulatory network in ABA responses: Sensing, signaling and transport. Plant Cell Physiol. 2010, 51, 1821–1839. [Google Scholar] [CrossRef] [PubMed]
- Song, L.; Huang, S.C.; Wise, A.; Castanon, R.; Nery, J.R.; Chen, H.; Watanabe, M.; Thomas, J.; Bar-Joseph, Z.; Ecker, J.R. A transcription factor hierarchy defines an environmental stress response network. Science 2016, 354, aag1550. [Google Scholar] [CrossRef]
- Fujii, H.; Zhu, J.K. Arabidopsis mutant deficient in 3 abscisic acid-activated protein kinases reveals critical roles in growth, reproduction, and stress. Proc. Natl. Acad. Sci. USA 2009, 106, 8380–8385. [Google Scholar] [CrossRef]
- Soon, F.F.; Ng, L.M.; Zhou, X.E.; West, G.M.; Kovach, A.; Tan, M.E.; Suino-Powell, K.M.; He, Y.; Xu, Y.; Chalmers, M.J. Molecular mimicry regulates ABA signaling by SnRK2 kinases and PP2C phosphatases. Science 2012, 335, 85–88. [Google Scholar] [CrossRef]
- Guo, J.; Wang, S.; Valerius, O.; Hall, H.; Zeng, Q.; Li, J.F.; Weston, D.J.; Ellis, B.E.; Chen, J.-G. Involvement of Arabidopsis RACK1 in protein translation and its regulation by abscisic acid. Plant Physiol. 2011, 155, 370–383. [Google Scholar] [CrossRef]
- Rushton, D.L.; Tripathi, P.; Rabara, R.C.; Lin, J.; Ringler, P.; Boken, A.K.; Langum, T.J.; Smidt, L.; Boomsma, D.D.; Emme, N.J. WRKY transcription factors: Key components in abscisic acid signalling. Plant Biotechnol. J. 2012, 10, 2–11. [Google Scholar] [CrossRef] [PubMed]
- Grandellis, C.; Fantino, E.; García, M.N.M.; Bialer, M.G.; Santin, F.; Capiati, D.A.; Ulloa, R.M. StCDPK3 phosphorylates in vitro two transcription factors involved in GA and ABA signaling in potato: StRSG1 and StABF1. PLoS ONE 2016, 11, e0167389. [Google Scholar] [CrossRef] [PubMed]
- Gosti, F.; Beaudoin, N.; Serizet, C.; Webb, A.A.; Vartanian, N.; Giraudat, J. ABI1 protein phosphatase 2C is a negative regulator of abscisic acid signaling. Plant Cell 1999, 11, 1897–1909. [Google Scholar] [CrossRef] [PubMed]
- Fujii, H.; Verslues, P.E.; Zhu, J.K. Identification of two protein kinases required for abscisic acid regulation of seed germination, root growth, and gene expression in Arabidopsis. Plant Cell 2007, 19, 485–494. [Google Scholar] [CrossRef] [PubMed]
- Yoshida, T.; Fujita, Y.; Sayama, H.; Kidokoro, S.; Maruyama, K.; Mizoi, J.; Shinozaki, K.; Yamaguchi-Shinozaki, K. AREB1, AREB2, and ABF3 are master transcription factors that cooperatively regulate ABRE-dependent ABA signaling involved in drought stress tolerance and require ABA for full activation. Plant J. 2010, 61, 672–685. [Google Scholar] [CrossRef]
- Yoshida, T.; Fujita, Y.; Maruyama, K.; Mogami, J.; Todaka, D.; Shinozaki, K.; Yamaguchi-Shinozaki, K. Four Arabidopsis AREB/ABF transcription factors function predominantly in gene expression downstream of SnRK2 kinases in abscisic acid signalling in response to osmotic stress. Plant Cell Environ. 2015, 38, 35–49. [Google Scholar] [CrossRef]
- Hussain, Q.; Asim, M.; Zhang, R.; Khan, R.; Farooq, S.; Wu, J. Transcription Factors Interact with ABA through Gene Expression and Signaling Pathways to Mitigate Drought and Salinity Stress. Biomolecules 2021, 11, 1159. [Google Scholar] [CrossRef]
- Tian, H.; Chen, S.; Yang, W.; Wang, T.; Zheng, K.; Wang, Y.; Cheng, Y.; Zhang, N.; Liu, S.; Li, D.; et al. A novel family of transcription factors conserved in angiosperms is required for ABA signalling. Plant Cell Environ. 2017, 40, 2958–2971. [Google Scholar] [CrossRef]
- Lee, J.H.; Yoon, H.J.; Terzaghi, W.; Martinez, C.; Dai, M.; Li, J.; Byun, M.-O.; Deng, X.W. DWA1 and DWA2, two Arabidopsis DWD protein components of CUL4-based E3 ligases, act together as negative regulators in ABA signal transduction. Plant Cell 2010, 22, 1716–1732. [Google Scholar] [CrossRef]
- Ahmad, R.; Liu, Y.; Wang, T.J.; Meng, Q.; Yin, H.; Wang, X.; Wu, Y.; Nan, N.; Liu, B.; Xu, Z.Y. GOLDEN2-LIKE transcription factors regulate WRKY40 expression in response to abscisic acid. Plant Physiol. 2019, 179, 1844–1860. [Google Scholar] [CrossRef]
- Nijhawan, A.; Jain, M.; Tyagi, A.K.; Khurana, J.P. Genomic survey and gene expression analysis of the basic leucine zipper transcription factor family in rice. Plant Physiol. 2008, 146, 333. [Google Scholar] [CrossRef] [PubMed]
- Jakoby, M.; Weisshaar, B.; Dröge-Laser, W.; Vicente-Carbajosa, J.; Tiedemann, J.; Kroj, T.; Parcy, F. bZIP transcription factors in Arabidopsis. Trends Plant Sci. 2002, 7, 106–111. [Google Scholar] [CrossRef]
- Vincentz, M.; Bandeira-Kobarg, C.; Gauer, L.; Schlögl, P.; Leite, A. Evolutionary pattern of angiosperm bZIP factors homologous to the maize Opaque2 regulatory protein. J. Mol. Evol. 2003, 56, 105–116. [Google Scholar] [CrossRef] [PubMed]
- Foster, R.; Izawa, T.; Chua, N.H. Plant bZIP proteins gather at ACGT elements. FASEB J. 1994, 8, 192–200. [Google Scholar] [CrossRef]
- Sibéril, Y.; Doireau, P.; Gantet, P. Plant bZIP G-box binding factors. Modular structure and activation mechanisms. Eur. J. Biochem. 2001, 268, 5655–5666. [Google Scholar] [CrossRef]
- Dröge-Laser, W.; Snoek, B.L.; Snel, B.; Weiste, C. The Arabidopsis bZIP transcription factor family-an update. Curr. Opin. Plant Biol. 2018, 45, 36–49. [Google Scholar] [CrossRef]
- Silveira, A.B.; Gauer, L.; Tomaz, J.P.; Cardoso, P.R.; Carmello-Guerreiro, S.; Vincentz, M. The Arabidopsis AtbZIP9 protein fused to the VP16 transcriptional activation domain alters leaf and vascular development. Plant Sci. 2007, 172, 1148–1156. [Google Scholar] [CrossRef]
- Ordoñez-Herrera, N.; Trimborn, L.; Menje, M.; Henschel, M.; Robers, L.; Kaufholdt, D.; Hänsch, R.; Adrian, J.; Ponnu, J.; Hoecker, U. The transcription factor COL12 is a substrate of the COP1/SPA E3 ligase and regulates flowering time and plant architecture. Plant Physiol. 2018, 176, 1327–1340. [Google Scholar] [CrossRef]
- Gibalová, A.; Steinbachová, L.; Hafidh, S.; Bláhová, V.; Gadiou, Z.; Michailidis, C.; Műller, K.; Pleskot, R.; Dupľáková, N.; Honys, D. Characterization of pollen-expressed bZIP protein interactions and the role of ATbZIP18 in the male gametophyte. Plant Reprod. 2017, 30, 1–17. [Google Scholar] [CrossRef]
- Lozano-Sotomayor, P.; Chávez Montes, R.A.; Silvestre-Vañó, M.; Herrera-Ubaldo, H.; Greco, R.; Pablo-Villa, J.; Galliani, B.M.; Diaz-Ramirez, D.; Weemen, M.; Boutilier, K. Altered expression of the bZIP transcription factor DRINK ME affects growth and reproductive development in Arabidopsis thaliana. Plant J. 2016, 88, 437–451. [Google Scholar] [CrossRef]
- Iglesias-Fernández, R.; Barrero-Sicilia, C.; Carrillo-Barral, N.; Oñate-Sánchez, L.; Carbonero, P. Arabidopsis thaliana bZIP 44: A transcription factor affecting seed germination and expression of the mannanase-encoding gene AtMAN7. Plant J. 2013, 74, 767–780. [Google Scholar] [CrossRef] [PubMed]
- Guo, Y.; Gan, S.S. Translational researches on leaf senescence for enhancing plant productivity and quality. J. Exp. Bot. 2014, 65, 3901–3913. [Google Scholar] [CrossRef] [PubMed]
- Gao, S.; Gao, J.; Zhu, X.; Song, Y.; Li, Z.; Ren, G.; Zhou, X.; Kuai, B. ABF2, ABF3, and ABF4 promote ABA-mediated chlorophyll degradation and leaf senescence by transcriptional activation of chlorophyll catabolic genes and senescence-associated genes in Arabidopsis. Mol. Plant 2016, 9, 1272–1285. [Google Scholar] [CrossRef] [PubMed]
- Dietrich, K.; Weltmeier, F.; Ehlert, A.; Weiste, C.; Stahl, M.; Harter, K.; Dröge-Laser, W. Heterodimers of the Arabidopsis transcription factors bZIP1 and bZIP53 reprogram amino acid metabolism during low energy stress. Plant Cell 2011, 23, 381–395. [Google Scholar] [CrossRef] [PubMed]
- Smykowski, A.; Zimmermann, P.; Zentgraf, U. G-Box binding factor1 reduces CATALASE2 expression and regulates the onset of leaf senescence in Arabidopsis. Plant Physiol. 2010, 153, 1321–1331. [Google Scholar] [CrossRef]
- Shin, D.H.; Choi, M.; Kim, K.; Bang, G.; Cho, M.; Choi, S.B.; Choi, G.; Park, Y.I. HY5 regulates anthocyanin biosynthesis by inducing the transcriptional activation of the MYB75/PAP1 transcription factor in Arabidopsis. FEBS Lett. 2013, 587, 1543–1547. [Google Scholar] [CrossRef]
- Banerjee, A.; Roychoudhury, A. Abscisic-acid-dependent basic leucine zipper (bZIP) transcription factors in plant abiotic stress. Protoplasma 2017, 254, 3–16. [Google Scholar] [CrossRef]
- Sun, X.; Li, Y.; Cai, H.; Bai, X.; Ji, W.; Ding, X.; Zhu, Y. The Arabidopsis AtbZIP1 transcription factor is a positive regulator of plant tolerance to salt, osmotic and drought stresses. J. Plant Res. 2012, 125, 429–438. [Google Scholar] [CrossRef]
- Liu, J.X.; Srivastava, R.; Howell, S.H. Stress-induced expression of an activated form of AtbZIP17 provides protection from salt stress in Arabidopsis. Plant Cell Environ. 2008, 31, 1735–1743. [Google Scholar] [CrossRef]
- Yang, O.; Popova, O.; Süthoff, U.; Lüking, I.; Dietz, K.J.; Golldack, D. The Arabidopsis basic leucine zipper transcription factor AtbZIP24 regulates complex transcriptional networks involved in abiotic stress resistance. Gene 2009, 436, 45–55. [Google Scholar] [CrossRef]
- Roychoudhury, A.; Paul, A. Abscisic acid-inducible genes during salinity and drought stress. Adv. Med. Biol. 2012, 51, 1–78. [Google Scholar]
- Kim, S.; Kang, J.Y.; Cho, D.I.; Park, J.H.; Kim, S.Y. ABF2, an ABRE-binding bZIP factor, is an essential component of glucose signaling and its overexpression affects multiple stress tolerance. Plant J. 2004, 40, 75–87. [Google Scholar] [CrossRef] [PubMed]
- Tsugama, D.; Liu, S.; Takano, T. A bZIP protein, VIP1, is a regulator of osmosensory signaling in Arabidopsis. Plant Physiol. 2012, 159, 144–155. [Google Scholar] [CrossRef] [PubMed]
- Rolly, N.K.; Imran, Q.M.; Lee, I.-J.; Yun, B.W. Salinity stress-mediated suppression of expression of salt overly sensitive signaling pathway genes suggests negative regulation by AtbZIP62 transcription factor in Arabidopsis thaliana. Int. J. Mol. Sci. 2020, 21, 1726. [Google Scholar] [CrossRef] [PubMed]
- Rolly, N.K.; Imran, Q.M.; Shahid, M.; Imran, M.; Khan, M.; Lee, S.U.; Hussain, A.; Lee, I.J.; Yun, B.-W. Drought-induced AtbZIP62 transcription factor regulates drought stress response in Arabidopsis. Plant Physiol. Biochem. 2020, 156, 384–395. [Google Scholar] [CrossRef]
- Rolly, N.K.; Yun, B.-W. Regulation of nitrate (NO3) transporters and glutamate synthase-encoding genes under drought stress in Arabidopsis: The regulatory role of AtbZIP62 transcription factor. Plants 2021, 10, 2149. [Google Scholar] [CrossRef]
- Nabi, R.B.S.; Rolly, N.K.; Tayade, R.; Khan, M.; Shahid, M.; Yun, B.-W. Enhanced resistance of atbzip62 against Pseudomonas syringae pv. tomato suggests negative regulation of plant basal defense and systemic acquired resistance by AtbZIP62 transcription factor. Int. J. Mol. Sci. 2021, 22, 11541. [Google Scholar] [CrossRef]
- Hu, Q.; Yang, L.; Liu, S.; Zhou, L.; Wang, X.; Wang, W.; Cai, L.; Wu, X.; Chang, Y.; Wang, S. A repressor motif-containing poplar R3 MYB-like transcription factor regulates epidermal cell fate determination and anthocyanin biosynthesis in Arabidopsis. J. Plant Biol. 2016, 59, 525–535. [Google Scholar] [CrossRef]
- Cheng, Y.; Zhang, N.; Hussain, S.; Ahmed, S.; Yang, W.; Wang, S. Integration of a FT expression cassette into CRISPR/Cas9 construct enables fast generation and easy identification of transgene-free mutants in Arabidopsis. PLoS ONE 2019, 14, e0218583. [Google Scholar] [CrossRef]
- Gorshkova, D.; Getman, I.; Voronkov, A.; Chizhova, S.; Kuznetsov, V.V.; Pojidaeva, E. The gene encoding the universal stress protein AtUSP is regulated by phytohormones and involved in seed germination of Arabidopsis thaliana. In Doklady Biochemistry and Biophysics; Springer: Berlin/Heidelberg, Germany, 2018; pp. 105–107. [Google Scholar]
- Boudsocq, M.; Barbier-Brygoo, H.; Lauriere, C. Identification of nine sucrose nonfermenting 1-related protein kinases 2 activated by hyperosmotic and saline stresses in Arabidopsis thaliana. J. Biol. Chem. 2004, 279, 41758–41766. [Google Scholar] [CrossRef]
- Fujita, Y.; Fujita, M.; Satoh, R.; Maruyama, K.; Parvez, M.M.; Seki, M.; Hiratsu, K.; Ohme-Takagi, M.; Shinozaki, K.; Yamaguchi-Shinozaki, K. AREB1 is a transcription activator of novel ABRE-dependent ABA signaling that enhances drought stress tolerance in Arabidopsis. Plant Cell 2005, 17, 3470–3488. [Google Scholar] [CrossRef] [PubMed]
- Furihata, T.; Maruyama, K.; Fujita, Y.; Umezawa, T.; Yoshida, R.; Shinozaki, K.; Yamaguchi-Shinozaki, K. Abscisic acid-dependent multisite phosphorylation regulates the activity of a transcription activator AREB1. Proc. Natl. Acad. Sci. USA 2006, 103, 1988–1993. [Google Scholar] [CrossRef] [PubMed]
- Zhou, Y.; Xu, D.; Jia, L.; Huang, X.; Ma, G.; Wang, S.; Zhu, M.; Zhang, A.; Guan, M.; Lu, K. Genome-wide identification and structural analysis of bZIP transcription factor genes in Brassica napus. Genes 2017, 8, 288. [Google Scholar] [CrossRef] [PubMed]
- Choi, H.I.; Hong, J.H.; Ha, J.O.; Kang, J.Y.; Kim, S.Y. ABFs, a family of ABA-responsive element binding factors. J. Biol. Chem. 2000, 275, 1723–1730. [Google Scholar] [CrossRef]
- Llorca, C.M.; Berendzen, K.W.; Malik, W.A.; Mahn, S.; Piepho, H.-P.; Zentgraf, U. The elucidation of the interactome of 16 Arabidopsis bZIP factors reveals three independent functional networks. PLoS ONE 2015, 10, e0139884. [Google Scholar] [CrossRef]
- Finkelstein, R.R.; Gampala, S.S.; Rock, C.D. Abscisic acid signaling in seeds and seedlings. Plant Cell 2002, 14, S15–S45. [Google Scholar] [CrossRef]
- Schumaker, K.S.; Sze, H. Inositol 1, 4, 5-trisphosphate releases Ca2+ from vacuolar membrane vesicles of oat roots. J. Biol. Chem. 1987, 262, 3944–3946. [Google Scholar] [CrossRef]
- Finkelstein, R.R.; Wang, M.L.; Lynch, T.J.; Rao, S.; Goodman, H.M. The Arabidopsis abscisic acid response locus ABI4 encodes an APETALA2 domain protein. Plant Cell 1998, 10, 1043–1054. [Google Scholar] [CrossRef]
- Urao, T.; Yamaguchi-Shinozaki, K.; Urao, S.; Shinozaki, K. An Arabidopsis myb homolog is induced by dehydration stress and its gene product binds to the conserved MYB recognition sequence. Plant Cell 1993, 5, 1529–1539. [Google Scholar]
- Kang, J.-Y.; Choi, H.I.; Im, M.Y.; Kim, S.Y. Arabidopsis basic leucine zipper proteins that mediate stress-responsive abscisic acid signaling. Plant Cell 2002, 14, 343–357. [Google Scholar] [CrossRef]
- Lopez-Molina, L.; Chua, N.H. A null mutation in a bZIP factor confers ABA-insensitivity in Arabidopsis thaliana. Plant Cell Physiol. 2000, 41, 541–547. [Google Scholar] [CrossRef] [PubMed]
- Wang, X.; Wang, X.; Hu, Q.; Dai, X.; Tian, H.; Zheng, K.; Wang, X.; Mao, T.; Chen, J.G.; Wang, S. Characterization of an activation-tagged mutant uncovers a role of GLABRA 2 in anthocyanin biosynthesis in Arabidopsis. Plant J. 2015, 83, 300–311. [Google Scholar] [CrossRef] [PubMed]
- Geraldes, A.; Pang, J.; Thiessen, N.; Cezard, T.; Moore, R.; Zhao, Y.; Tam, A.; Wang, S.; Friedmann, M.; Birol, I. SNP discovery in black cottonwood (Populus trichocarpa) by population transcriptome resequencing. Mol. Ecol. Resour. 2011, 11, 81–92. [Google Scholar] [CrossRef] [PubMed]
- Edwards, K.; Johnstone, C.; Thompson, C. A simple and rapid method for the preparation of plant genomic DNA for PCR Analysis. Nucl. Acids Res. 1991, 19, 1349. [Google Scholar] [CrossRef] [PubMed]
- Chen, S.; Zhang, N.; Zhang, Q.; Zhou, G.; Tian, H.; Hussain, S.; Ahmed, S.; Wang, T.; Wang, S. Genome editing to integrate seed size and abiotic stress tolerance traits in Arabidopsis reveals a role for DPA4 and SOD7 in the regulation of inflorescence architecture. Int. J. Mol. Sci. 2019, 20, 2695. [Google Scholar] [CrossRef]
- Liu, S.; Hu, Q.; Luo, S.; Li, Q.; Yang, X.; Wang, X.; Wang, S. Expression of wild-type PtrIAA14. 1, a poplar Aux/IAA gene causes morphological changes in Arabidopsis. Front. Plant Sci. 2015, 6, 388. [Google Scholar] [CrossRef]
- Tiwari, S.B.; Hagen, G.; Guilfoyle, T.J. Aux/IAA proteins contain a potent transcriptional repression domain. Plant Cell 2004, 16, 533–543. [Google Scholar] [CrossRef]
- Wang, X.Q.; Xu, W.H.; Ma, L.G.; Fu, Z.M.; Deng, X.W.; Li, J.Y.; Wang, Y.H. Requirement of KNAT1/BP for the development of abscission zones in Arabidopsis thaliana. J. Integr. Plant Biol. 2006, 48, 15–26. [Google Scholar] [CrossRef]
- Lee, Y.J.; Kim, D.H.; Kim, Y.W.; Hwang, I. Identification of a signal that distinguishes between the chloroplast outer envelope membrane and the endomembrane system in vivo. Plant Cell 2001, 13, 2175–2190. [Google Scholar] [CrossRef]
- Tian, H.; Guo, H.; Dai, X.; Cheng, Y.; Zheng, K.; Wang, X.; Wang, S. An ABA down-regulated bHLH transcription repressor gene, bHLH129 regulates root elongation and ABA response when overexpressed in Arabidopsis. Sci. Rep. 2015, 5, 17587. [Google Scholar] [CrossRef]
- Hajdukiewicz, P.; Svab, Z.; Maliga, P. The small, versatilepPZP family ofAgrobacterium binary vectors for plant transformation. Plant Mol. Biol. 1994, 25, 989–994. [Google Scholar] [CrossRef] [PubMed]
- Wang, Z.P.; Xing, H.L.; Dong, L.; Zhang, H.Y.; Han, C.Y.; Wang, X.C.; Chen, Q.J. Egg cell-specific promoter-controlled CRISPR/Cas9 efficiently generates homozygous mutants for multiple target genes in Arabidopsis in a single generation. Genome Biol. 2015, 16, 144. [Google Scholar] [CrossRef] [PubMed]
- Dai, X.; Zhou, L.; Zhang, W.; Cai, L.; Guo, H.; Tian, H.; Schiefelbein, J.; Wang, S. A single amino acid substitution in the R3 domain of GLABRA1 leads to inhibition of trichome formation in Arabidopsis without affecting its interaction with GLABRA3. Plant Cell Environ. 2016, 39, 897–907. [Google Scholar] [CrossRef] [PubMed]
- Tian, H.; Wang, X.; Guo, H.; Cheng, Y.; Hou, C.; Chen, J.G.; Wang, S. NTL8 regulates trichome formation in Arabidopsis by directly activating R3 MYB genes TRY and TCL1. Plant Physiol. 2017, 174, 2363–2375. [Google Scholar] [CrossRef] [PubMed]
- Wang, S.; Tiwari, S.B.; Hagen, G.; Guilfoyle, T.J. AUXIN RESPONSE FACTOR7 restores the expression of auxin-responsive genes in mutant Arabidopsis leaf mesophyll protoplasts. Plant Cell 2005, 17, 1979–1993. [Google Scholar] [CrossRef]
- Clough, S.J.; Bent, A.F. Floral dip: A simplified method for Agrobacterium-mediated transformation of Arabidopsis thaliana. Plant J. 1998, 16, 735–743. [Google Scholar] [CrossRef] [PubMed]
Publisher’s Note: MDPI stays neutral with regard to jurisdictional claims in published maps and institutional affiliations. |
© 2022 by the authors. Licensee MDPI, Basel, Switzerland. This article is an open access article distributed under the terms and conditions of the Creative Commons Attribution (CC BY) license (https://creativecommons.org/licenses/by/4.0/).